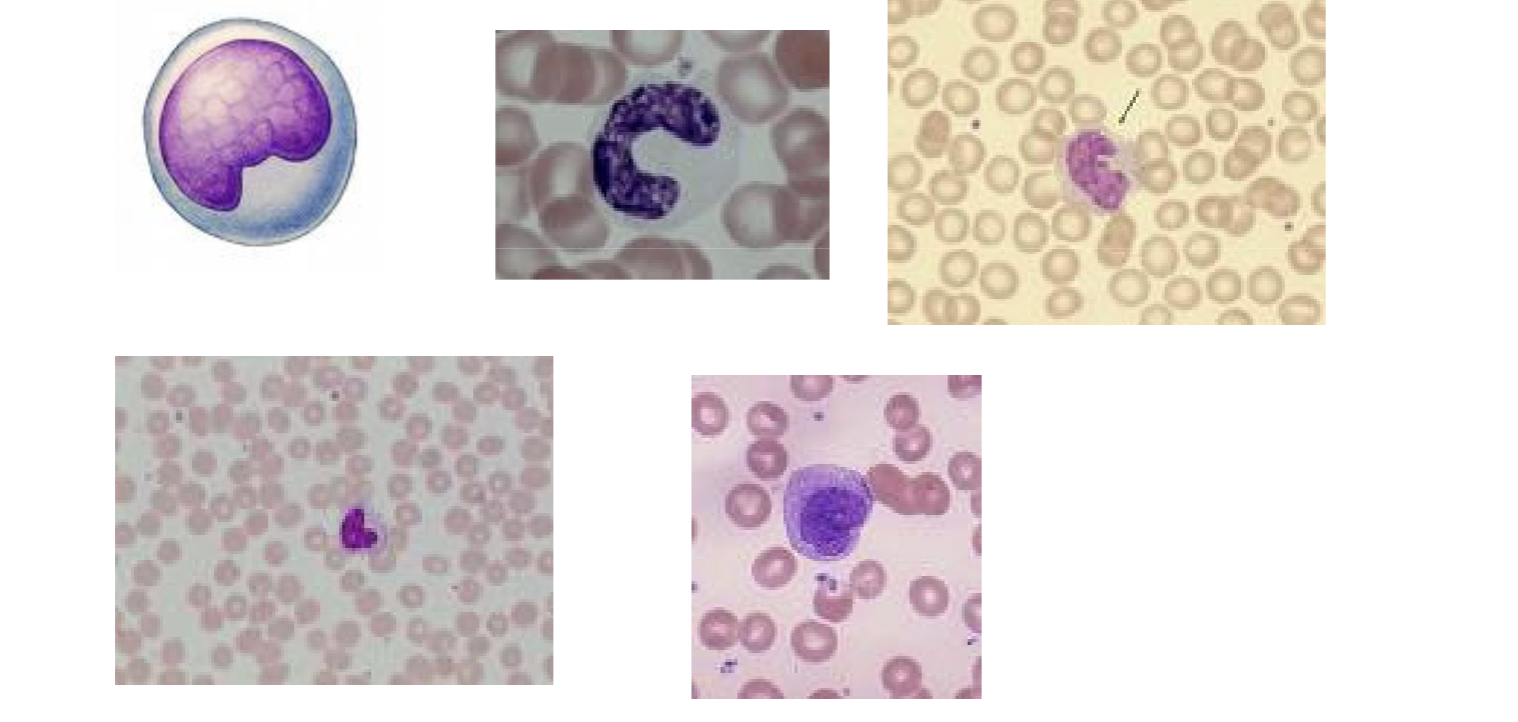
knowt flashcard image

Microscopic Leukocytes
0.0(0)
0.0(0)
Card Sorting
1/4
There's no tags or description
Looks like no tags are added yet.
Study Analytics
Name | Mastery | Learn | Test | Matching | Spaced |
|---|
No study sessions yet.
5 Terms
1
New cards
Neutrophils: fragmented nuclei

2
New cards
Eosinophils: bilobed nuclei; lobes
connected with thin strip

3
New cards
Basophils: dark, granulated nuclei.
Rare

4
New cards
Lymphocytes: small cells; large,
smooth nucleus with tiny sliver of
light purple cytoplasm

5
New cards
Monocytes: huge cells; thick,
kidney-shaped nucleus